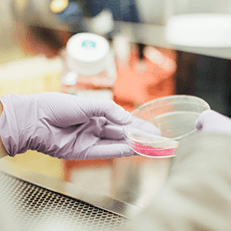

Mental health articles and information
Many people find that starting the conversation is the hardest part of addressing a psychological issue, so we’ve done it for you. You’ll find lots of advice on dealing with depression, anxiety, stress and other common mental health conditions, all backed by our smart network of UK doctors.

6 Mental Health Benefits of Plants

What are the UK’s 10 most common phobias?

How to improve concentration: Focus Foods

How to improve concentration: Focus Foods 1

How to improve concentration: Focus Foods 3

How to improve concentration: Focus Foods 2

How to improve concentration: Focus Foods 4

What’s the link between IBS and mental health?

How can you hear your own voice inside your head?

7 Reasons Why You Can't Sleep At Night, Without Even Realising

Can growing a beard benefit a man’s health?

6 stress management techniques to try at home

Staying Sharp: How to Look After Your Brain

4 unusual ways to improve your mental health

Blue Monday: How you can deal with the most depressing day of the year

How to get a good night's sleep - 43 ways to sleep better

How to de-stress with healthy recipes: Tastes Good, Does Good

How to deal with stress: 42 stress management tips

Mental Health Awareness: Ask The Doctor

6 mental health benefits of plants: Does Flower Power boost your mood?

How To Break Bad Habits: A Guide To Rewiring Your Brain

How Friendship Affects Your Health: Stress, Sharing & Good Habits

7 reasons why baking is great for your mental health

Push for Happiness: Work out your mental health

Mental Health: Speak out and see the difference

Push for Happiness - Food and your mood

How to deal with homesickness at university

Have yourself a stress-free Christmas

How to manage your mind: A doctor's guide

How to Sleep Well & Conquer Stress with Dr Punam Krishan

What makes you happy?

Knitting helps reduce depression, anxiety and chronic pain

What is emotional intelligence?

How to get rid of anxiety

How does your memory work?

Time for you - The ultimate guide to caring for yourself

What is stress?

Everything you need to know about Seasonal Affective Disorder (SAD)

Insomnia & Sleep Anxiety

5 Recent Breakthroughs in British Medical Research
Read these articles next

What’s the link between IBS and mental health?

How can you hear your own voice inside your head?

7 Reasons Why You Can't Sleep At Night, Without Even Realising

Can growing a beard benefit a man’s health?

6 stress management techniques to try at home

Staying Sharp: How to Look After Your Brain

What are the UK’s 10 most common phobias?

4 unusual ways to improve your mental health

How to improve concentration: Focus Foods

Blue Monday: How you can deal with the most depressing day of the year

How to get a good night's sleep - 43 ways to sleep better

How to de-stress with healthy recipes: Tastes Good, Does Good

How to deal with stress: 42 stress management tips

Mental Health Awareness: Ask The Doctor

6 mental health benefits of plants: Does Flower Power boost your mood?

How To Break Bad Habits: A Guide To Rewiring Your Brain

How Friendship Affects Your Health: Stress, Sharing & Good Habits

7 reasons why baking is great for your mental health

Push for Happiness: Work out your mental health

Mental Health: Speak out and see the difference

Push for Happiness - Food and your mood

How to deal with homesickness at university

Have yourself a stress-free Christmas

How to manage your mind: A doctor's guide

How to Sleep Well & Conquer Stress with Dr Punam Krishan

What makes you happy?

Knitting helps reduce depression, anxiety and chronic pain

What is emotional intelligence?

How to get rid of anxiety

How does your memory work?

Time for you - The ultimate guide to caring for yourself

What is stress?

Everything you need to know about Seasonal Affective Disorder (SAD)

Insomnia & Sleep Anxiety
5 Recent Breakthroughs in British Medical Research

6 Mental Health Benefits of Plants

How to improve concentration: Focus Foods 1

How to improve concentration: Focus Foods 3

How to improve concentration: Focus Foods 2

How to improve concentration: Focus Foods 4
Subscribe
Travel inspired storytelling, seeking to showcase the people, trends and topics that inspire us to explore the world.
By clicking "Subscribe," I agree to the PushDr Terms and Conditions and Privacy Policy.
